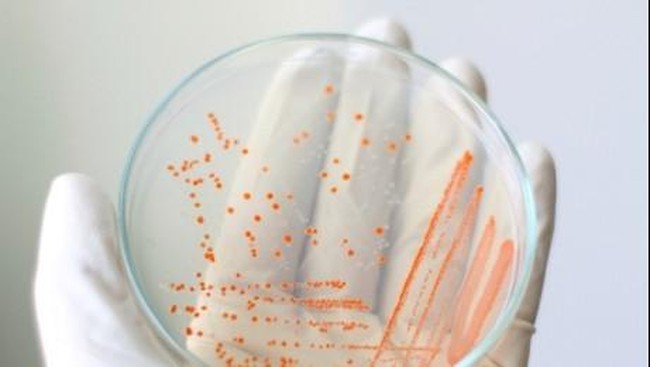
Kasus-kasus Infeksi Bakteri Pemakan Daging dari Berbagai Belahan Dunia

Efek berbahaya seperti itu dapat juga disebabkan oleh beberapa bakteri seperti E. coli dan Staphylococcus. Bakteri biasanya berdampak terhadap orang-orang dengan sistem kekebalan tubuh yang lemah, namun individu yang sehat dapat mengalami infeksi juga.
Jika terlambat ditangani, bukan tak mungkin pasien akan meninggal dunia. Ketika akhirnya tertangani pun, hampir seluruh pasien kehilangan salah satu anggota tubuh seperti kaki, tangan hingga separuh wajah.
ADVERTISEMENT
SCROLL TO CONTINUE WITH CONTENT
1. Kerongkongan berlubang
|
Foto: Russel Carter
|
Awalnya, Russel jatuh sakit lima tahun lalu. Kala itu, ia tengah bekerja sebagai pengatur bagasi di bandara Gatwick. Russel mengalami nyeri di bagian punggung sampai ke bawah dan pneumonia. Di awal, dokter mendiagnosa ayah dua anak ini dengan pembekuan darah. Namun, obat yang diresepkan justru membuat ulkus duodenumnya pecah.
Selama setahun, Russel sudah menjalani 27 kali operasi pembukaan kerongkongan. Tapi karena kondisinya terlalu lemah dan esophagusnya hancur, paru-parunya selalu terisi air setiap ia minum. Kemudian, dokter pun menggunakan kulit babi untuk mengganti esophagus yang hancur.
Lubang kerongkongan Russel pun berkurang menjadi separuhnya sehingga proses makan agak terganggu dan bobotnya turun sampai 25 kg. Tak lama, tes laboratorium menunjukkan bahwa di kerongkongan Russel ada bakteri pemakan daging.
"Pengobatan atau pencegahan kondisi ini belum ada sehingga rasa sakit di ujung tenggorokanku yang kadang hilang bisa muncul tiba-tiba. Aku tak tahu berapa lama lagi aku bisa hidup mengingat kerongkonganku yang sudah berlubang karena digerogoti bakteri itu," terang Russel.
2. Kaki dan tangan hilang
|
Foto: Alex Lewis
|
Petugas medis mendiagnosis darah Alex terinfeksi streptokokus Grup A. Dalam kasus Alex, akibat infeksi bakteri itu berkembang menjadi septicemia dan toxic shock syndrome. Dokter bahkan sempat memperingatkan ia hanya memiliki tiga persen peluang untuk bertahan hidup. Septicemia adalah kondisi di mana dalam darah terdapat bakteri dan sering dikaitkan dengan penyakit berat.
Mulanya Alex dirawat di Royal County Hospital, di Winchester, Hants. Namun kemudian dia dipindahkan ke Salisbury District Hospital, Wilts. Saat itu pula dilakukan amputasi sebagai satu-satunya jalan untuk menyelamatkan hidup Alex.
Ahli bedah lantas memotong tiga anggota tubuh Alex dan mengambil otot dari punggungnya untuk membangun kembali lengan kanannya yang mati dalam serangkaian operasi melelahkan. Selanjutnya, Alex akan dipindahkan ke unit spesialis, di mana dirinya bisa mendapat kaki palsu dan menjalani rehabilitasi.
"Saya tidak menggunakan jari-jari saya, tapi tendon dan otot diharapkan bisa kembali bekerja," harap Alex.
3. Bakteri pemakan otak
|
Foto: thinkstock
|
Penyakit langka yang disebabkan oleh infeksi dari amoeba mikroskopis naegleria fowleri ini dapat menyerang sistem saraf pusat manusia. Dicurigai wanita itu terinfeksi amoeba ketika sedang berenang di Reno, Nevada.
Pejabat kesehatan Inyo Public Health mengonfirmasi kematian wanita yang identitasnya belum diketahui tersebut telah meninggal dunia di rumah sakit setempat. Ia mengaku terbangun di siang hari dengan gejala sakit kepala, mual dan muntah. Namun beberapa hari kemudian kondisinya memburuk sampai ia mengalami serangan jantung dan meninggal dunia.
4. Mata buta
|
Foto: thinkstock
|
Brittany mengatakan bahwa puing menciptakan luka pada matanya sehingga memungkinkan bakteri pemakan daging masuk dan menghancurkan korneanya. Ibu dengan dua profesi tetapi tanpa asuransi kesehatan ini menghabiskan waktu satu pekan di rumah sakit. Ia berutang uang sebesar sekitar Rp 1 miliar untuk biaya pengobatannya.
Brittany tetap optimistis terlepas dari kesakitan yang dirasakannya. Meskipun menghadapi hal yang buruk, ia akan melaluinya dengan terbaik yang bisa dilakukan. "Tidak ada gunanya hanya duduk dan cemberut karena hanya akan membuat hari-hari menjadi lebih menyedihkan," imbuh Brittany.
5. Otot tangan dan kaki hilang
|
Foto: thinkstock
|
Ibu dua anak dan eks marinir ini sedang berjuang untuk hidupnya dengan melawan bakteri pemakan daging. Dokter telah memperingatkan bahwa ia mungkin akan kehilangan anggota tubuhnya.
Teman dan keluarga Cindy kini bersandar pada keyakinan melalui cobaan ini. Mereka hanya mampu berdoa untuk keajaiban lainnya dan berusaha menerima kemungkinan Cindy akan kehilangan tangan dan kakinya.
6. Meninggal tertusuk sungut lele
|
Foto: thinkstock
|
Tak disangka, sungut lele tersebut ternyata mengandung bakteri vibrio vulnificus, salah satu bakteri pemakan daging yang memang hidup di sungai. Bakteri ini menginfeksi tubuh Horner dari luka di bagian kakinya dan menyebar ke seluruh tubuh dalam waktu beberapa hari saja.
Dokter setempat sudah berusaha menyelamatkan nyawa Horner dengan mengamputasi kakinya. Namun ternyata, bakteri tersebut sudah menyebar ke seluruh tubuhnya.
Kasus yang terjadi pada Horner merupakan kasus kematian akibat bakteri vibrio vulnificus pertama di Virginia untuk tahun 2015. Data Centers for Disease Control and Prevention (CDC) Amerika Serikat menyebut sudah ada 17 korban lain dari berbagai negara bagian.
Halaman 2 dari 7